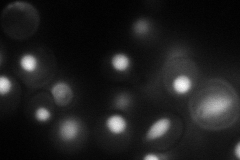
YHR156C
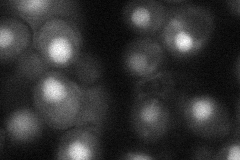
YHR156C

View description
Non-essential component of U5 snRNP; nuclear protein; physically interacts with Irr1p of cohesin complex; may link together proteins involved in chromosome segregation, mRNA splicing and DNA replication
Localization:
Intensity:
Fold change:
Significance:
-
C’ GFP library in SD

nucleus16.79 -
N' NOP1pr-GFP in SD
nucleus63.8643 -
N' TEF2pr-mCherry in SD

nucleus118.715 -
N' NATIVEpr-GFP in SD

nucleus21.2443 -
N' TEF2pr-VC and Cyto-VN in SD
nucleus42.5961 -
C’ GFP library in SD+DTT

nucleus18.981.13No -
C’ GFP library in SD+H2O2

nucleus18.351.09No -
C’ GFP library in Starvation Media

nucleus18.171.08No -
C’ GFP library on the background of Pup2-DaMP

nucleus -
C’ GFP library on the background of CCT mutant

nucleus18.53871.10395No
